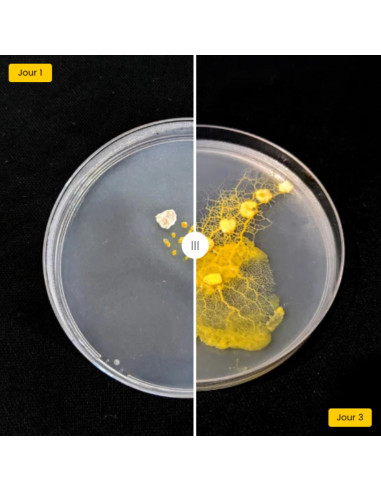
Coffret d'élevage de blob - La Blob Box

Carrito
Coffret d'élevage de blob - La Blob Box
BLOB_BOX
24,17 € impuestos excl.
29,00 €
Impuestos incluidos
La Blob Box de Mister Blob est un kit prêt à l’emploi pour élever et observer le blob, un organisme unicellulaire fascinant capable d’apprendre sans cerveau. Ce coffret permet aux enfants et débutants de découvrir la biologie de manière ludique et interactive.
Avantages pédagogiques
- Stimule la curiosité scientifique
- Favorise l’apprentissage par l’observation et l’expérimentation
- Développe l’autonomie et le sens des responsabilités
- Facile à utiliser, adapté aux écoles et à la maison
La Blob Box offre une expérience simple et captivante pour explorer un organisme unique tout en apprenant.
Ce que contient la Blob Box
- 4 boîtes de Petri pour bien démarrer l’élevage.
- 2 sclérotes de blob prêts à être réveillés.
- Flocons d’avoine et agar-agar pour nourrir et héberger le blob.
- Outils d’élevage : pince, pipette et cuillère doseuse de 1 g.
- Un guide complet pour vous accompagner de l’éveil du blob jusqu’à sa mise en dormance.
Cette composition complète facilite l’observation et le soin du blob dans les meilleures conditions.
Idées d'activités à faire avec son blob
- Labyrinthe : Construisez un labyrinthe (avec des Lego ou pâte à modeler) dans une boîte de Petri, placez le blob à une entrée et un flocon d’avoine à la sortie, puis observez sa capacité à trouver le chemin.
- Préférences alimentaires : Placez différents aliments (flocons d’avoine, fruits, légumes, sucre, etc.) à égale distance autour du blob et observez lequel il préfère rejoindre en premier.
- Carte géographique : Reproduisez une carte (par exemple, la France) avec des points de nourriture sur les grandes villes et observez comment le blob relie les points, simulant un réseau de transport.
- Pont de sel : Placez un obstacle de sel entre le blob et sa nourriture pour tester sa capacité à franchir une barrière répulsive.
- Observation au microscope : Étudiez ses déplacements et sa croissance à l’aide d’un microscope numérique.
- Division et fusion : Coupez le blob en deux pour obtenir deux blobs, puis observez ce qu’il se passe lorsqu’ils se retrouvent côte à côte.
Ces activités permettent d’aborder la démarche scientifique, la curiosité et l’observation tout en s’amusant avec un organisme fascinant.
Découvrez le blob en quelque minutes
También podría interesarle